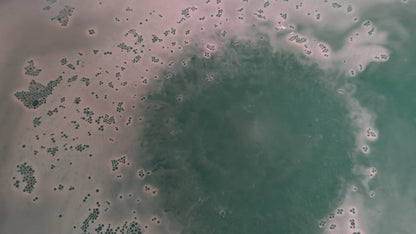
Decadent Bath Bomb
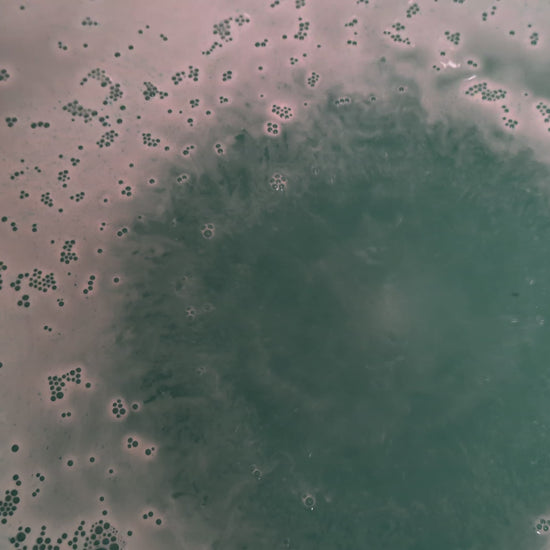

Bombshell Cosmetics
Decadent Bath Bomb
Decadent Bath Bomb
Couldn't load pickup availability
Indulge with Our Decadent Bath Bomb
Based on Marc Jacobs Decadence, this sensual floral scented bath bomb is a gorgeous teal and gold providing a truly decadent experience
Ultimate Relaxation Experience
Our luxurious bath bomb is designed to transform your bathing routine into a serene escape. With its fizzing action and delightful fragrances, this bath bomb enhances your relaxation experience. Just drop it into warm water, and watch as it dissolves, releasing nourishing oils and calming scents that help you unwind after a long day. As a result, you'll feel rejuvenated and ready to embrace life once more.
Natural Ingredients for Healthier Skin
This bath bomb is made with natural ingredients that not only smell wonderful but also benefit your skin. Ingredients such as coconut oil and essential oils nourish the skin, leaving it soft and hydrated. Therefore, you can indulge guilt-free knowing your self-care routine is also good for your skin. Our bath bomb is perfect for anyone seeking a little extra pampering.
Perfect Gift for Any Occasion
Looking for the ideal gift? Our decadent bath bomb makes a thoughtful choice for birthdays, holidays, or just because. Its beautiful packaging and delightful aroma make it appealing to all ages. Plus, everyone deserves a bit of relaxation and luxury in their life, so gifting our bath bomb is a wonderful way to show you care. In summary, whether for yourself or a loved one, this bath bomb is a surefire hit.
Share